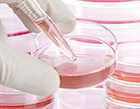
THE CLINIC(ザクリニック) が選ばれている理由3

症例
-

女性/35歳 -

女性/40歳 -

女性/44歳
| 施術名 | コンデンスセルチャー豊胸 |
|---|---|
| 施術概要 | 事前に太ももなどから20ml程度の脂肪を採取し幹細胞を抽出、培養する。2週間後、老化細胞や血液等の不純物を除去した脂肪にこれを加え、バストの皮下に注入する。 |
| 施術費用 (標準モニター) |
¥1,540,000(税込 ¥1,694,000) モニター募集に関して詳しくはこちらをご覧ください。 ▷【コンデンスセルチャー豊胸モニター募集】 |
| 施術の副作用・リスク | 施術後には一定期間、痛み、浮腫み、内出血、こわばり等の症状が見られることがあります。また、この他にも予期しない症状が現れる可能性がありますので、術後異常を感じた際には速やかにご相談ください。 |
THE CLINIC が選ばれている理由
脂肪注入豊胸の技術指導クリニック
THE CLINIC はCRF協会から国内ドクターへの技術指導を任されています。今まで250名以上ドクターを指導してきました。

他院の豊胸の失敗修正も多数経験
豊胸手術は受けても、難易度が高い失敗修正手術は受けないクリニックもありますが、当院は積極的に行っています。

再生医療を扱うクリニック
THE CLINIC は細胞加工サービスに関して正式な届出をした上で再生医療豊胸を提供しています。
ベイザー脂肪吸引では世界3つの資格を全医師が保有
当院は、全ドクターがベイザー脂肪吸引の世界的な資格3つを保有。脂肪注入豊胸で欠かせないの脂肪吸引にも自信があります。

痩せた方でも対応可能
BMI※が18未満のかなり痩せた方にも、安全に失敗なく施術を行なった実績があります。

※ BMI:体重( kg)÷身長(m)2で算出する、肥満の程度を表す指標。18.5を下回ると「痩せ型」とされる。
セルチャー豊胸の特徴
脂肪注入豊胸の効果に脂肪幹細胞が大きく関係することは、今では広く知られています。実際、単に脂肪を注入したケースに比べ、脂肪幹細胞をプラスした方が定着量が5倍に高まったという報告もあるほどです。
コンデンスセルチャー豊胸は、この脂肪幹細胞のチカラに着目し、THE CLINIC が満を持して導入した新施術です。

より多くの脂肪を注入できる
これまで脂肪幹細胞を注入する豊胸術と言えば、自動抽出器で抽出した脂肪幹細胞を注入脂肪に加える方法。この脂肪幹細胞注入法だと、片胸100mL、両胸だと200mLの脂肪が余計に必要となります。
その点、コンデンスセルチャー豊胸(培養幹細胞豊胸)では、幹細胞の抽出と培養に必要な脂肪量はわずか20mLと、脂肪幹細胞注入法の実に1/10。抽出した脂肪幹細胞をそのまま使用するのではなく増殖させるので、多くの脂肪は必要としません。つまり、その分バストへの注入に脂肪を活用できるというわけです。
- 脂肪加工プロセスの違い
-

脂肪幹細胞量が7.5倍
通常、200mLの脂肪に含まれる幹細胞の数は130万個です。一方、セルチャー豊胸では20mLの脂肪から取り出した幹細胞を培養して、1,000万個にまで増やします。
つまり、10分の1の脂肪量から7.5倍近い脂肪幹細胞を得られるということになります。

- 両胸の脂肪採取量と脂肪幹細胞量の比較
-

コンデンスリッチ豊胸と併用
脂肪注入豊胸では、せっかく注入した脂肪が壊死してしまわないためにも、注入量への配慮が必要です。個人の皮膚の伸展にもよりますが、一度の施術で片胸に注入できる脂肪量は200〜250mL程度。ここに肥大化した老化細胞や不純物が含まれていると、その分の体積がムダとなり効果にも影響します。
そこでTHE CLINIC のコンデンスセルチャー豊胸(培養幹細胞注入)では、コンデンスリッチ豊胸を併用します。健康な脂肪細胞を濃縮したCRF(コンデンスリッチファット)には、従来の脂肪注入法の1.4倍以上もの細胞が含まれているため、より高い効果が期待できるのです。
幹細胞密度の違い
- 従来の脂肪注入豊胸
-

不純物や老化細胞が除去しきれてないため、体積あたりの健全な細胞数が少ない
- コンデンスリッチ豊胸
-

不純物や肥大化した老化細胞の排除で密度が高まり、体積あたりの健全な細胞数が多い
そもそも幹細胞とは?
幹細胞は、特定の細胞に分化する能力を持つ細胞です。言わば、組織や臓器にもなり得る細胞のこと。世界中で様々な幹細胞が研究されていますが、代表的なものには以下の4つがあげられます。
-
- iPS細胞
- 体細胞といくつかの遺伝子でつくる人工的な幹細胞。
-
- ES細胞
- ヒトの胚(受精卵)から抽出した細胞の塊を培養する幹細胞。
-
- HS細胞
- 骨髄に存在し血球細胞に分化。白血病治療に活用。
-
- ADS細胞
- 脂肪幹細胞。HS細胞の100〜1000倍を脂肪から採取可能。
THE CLINIC は論文発表や学会発表などの学術的な活動も積極的に行っています。
論文発表
| 年 代 | 雑誌名 | タイトル | 著 者 |
|---|---|---|---|
| 2018 | Plastic and Reconstructive Surgery GO | Ultrasound Diagnosis and Treatment of Breast Lumps after Breast Augmentation with Autologous Fat Grafting | 志田雅明、千葉明彦、大橋昌敬、山川雅之 |
| Plastic and Reconstructive Surgery GO | Serial Injections of Cryopreserved Fat at −196ºC for Tissue Rejuvenation, Scar Treatment, and Volume Augmentation | 大橋昌敬、中居弘一、千葉明彦、福田越 | |
| 2016 | Plastic and Reconstructive Surgery GO | Our Experience with 131 Cases of Simultaneous Breast Implant Exhange with Fat(SIEF) | 大橋昌敬、山川雅之、千葉明彦 |
| 2015 | 日本美容外科学会誌 51巻1号 | Brava(External pre-expansion of the breast device)とコンデンスリッチ豊胸に併用療法に関する短期成績 | 大橋昌敬、山川雅之、千葉明彦 |
| 2013 | 日本美容外科学会誌 49巻2号 | 加重遠心分離した自家脂肪を用いた豊胸術(コンデンスリッチ豊胸)642例の短期成績:特に注入術後のバストサイズの変化に関して | 大橋昌敬、山川雅之 |
| 2011 | 日本美容外科学会誌 48巻1号 | LIPOMAX-SCを用い,加重遠心分離した自家脂肪を用いた軟部組織増大術(コンデンスリッチ豊胸500症例超,及び新しいフィラー:マイクロCRF60症例超の経験) | 大橋昌敬、山川雅之 |
学会発表
| 年 代 | 学会名 | タイトル | 発表者 |
|---|---|---|---|
| 2017 | 第105回日本美容外科学会 | -196℃で保存した脂肪-FatBankを使った治療(若返り・瘢痕・組織増大)〜SRF(Stem Cell Rich Fat:脂肪幹細胞が豊富な脂肪)の使用経験を含め〜 | 大橋昌敬 |
| 2016 | 江蘇省医学会医師協会医学美容年会 | FAT GRAFTING AND STEM CELL BASED THERAPIES(脂肪注入と脂肪幹細胞を用いた治療に関して) | 山川雅之 |
| 第104回日本美容外科学会 | 脂肪注入による豊胸のトレンド:しこり、脂肪壊死にならない為に〜分けて注入、脂肪保存(FATBANK)という選択肢〜 | 大橋昌敬 | |
| パンパシフィック外科協会(PPSA) | Simultaneous implant exchange & fat grafting Fat Graft to treat implant complications Fat Graft for primary breast enlargment BRAVA plus fat graft in China Fat Graft in breast reconstruction | 大橋昌敬 | |
| 2015 | 第3回日本乳房オンコプラスティックサージャリー学会 | 乳房再建術における自家脂肪移植の可能性 〜医療機器認証を受けたCRF(コンデンスリッチファット=加重遠心分離脂肪)移植による豊胸術の経験を生かして〜 | 大橋昌敬 |
| 日本美容外科学会誌 51巻1号 | Treatment strategy of breast lump after breast augmentation with autologous fat grafting | 千葉明彦 | |
| 第103回日本美容外科学会 | 自家脂肪移植による豊胸後のしこりの治療方針 | 千葉明彦 | |
| 第103回日本美容外科学会 | BRAVA(external pre-expansion of the breast device)とコンデンスリッチ豊胸の併用療法に関する短期成績 | 大橋昌敬 |
よくある質問
-
瘦せ型で十分な脂肪量を確保できるか不安なのですが、セルチャー豊胸を受けることは可能でしょうか?
セルチャー豊胸は、痩せている方にこそ適した豊胸術です。
痩せた方が脂肪注入豊胸を受ける際によく気にされるのは、どれだけ脂肪が定着してくれるかです。定着しないと、採取した脂肪は無駄になってしまいます。貴重な脂肪ですから、なるべく無駄にしたくないとお考えになるのはよくわかります。
その点、セルチャー豊胸で用いる脂肪には、脂肪の定着に有利に働く脂肪幹細胞が豊富に含まれています。加えて、幹細胞の抽出と培養に必要な脂肪量もわずか20ccたらず。このため、脂肪量の少ない痩せた方でもほとんど負担になりません。
もう一つ、特に痩せている方が気にされることと言えば「安全に、キレイに脂肪吸引できるか」でしょう。それについては、いくつかのクリニックでカウンセリングを受けていただき、医師の技量と、痩せた方に対する「慣れ」を見定めていただくのが良いでしょう。最もわかりやすい目安は症例数です。ちなみに当院のゲストの4人に1人はBMIが18.5未満の「痩せ型」です。日常的にこのような方たちを数多くお引き受けしています。痩せていることを理由に手術お断りすることは滅多にありませんのでご安心ください。 -
手術費用が少し高いように感じています。他の豊胸手術と比較したメリットが知りたいです。
一番の魅力は定着率の高さです。
セルチャー豊胸は脂肪注入豊胸の1つですが、脂肪から幹細胞を抽出・培養するという従来の豊胸術にないプロセスが加わるため、その分高額でのご案内になっています。
培養することで、少ない脂肪からより多くの幹細胞を作ることが可能になりました。
抽出した幹細胞を脂肪に付加する方法は以前から取られていましたが、培養することでその数は7.5倍に増えています。注入できる幹細胞が増えたことは、脂肪の定着に有利に働くと考えられます。
また、培養幹細胞は凍結保存できるので、複数回にわたって注入することも可能です。これによってさらなるバストアップが期待できるのはもちろん、最近では、乳がん手術後の乳房再建にも有効なのではないかと注目されていて、他院の形成外科の先生方との協力も進んでいます。
-
コンデンスセルチャー豊胸後のダウンタイムについて、具体的な症状や期間を教えてください。
幹細胞の抽出と培養のため、事前に20ccの脂肪を採取しますが、このとき吸引する脂肪はごく少量なのでダウンタイムはありません。シャワー・入浴については、ともに翌日から可能です。
豊胸手術の際に実施する脂肪吸引については、ダウンタイム症状として「きつめの筋肉痛」に近い痛みが術後3〜7日程度残ります。術後1週間頃には浮腫みやアザ(内出血)がピークを迎え、2週間頃から落ち着いてくるでしょう。その後、皮膚が引っ張られるような引きつれ感が生じますが、3カ月が経過する頃にはほとんど落ち着き、半年も経てば全く気にならなくなります。
脂肪注入に関しては、脂肪吸引ほど目立ったダウンタイムはありません。手術直後の約2週間は痛み、腫れ、アザ(内出血)が見られますが、1カ月程度で目立たなくなり、通常と変わらない生活が送れるようになります。
施術後のシャワー・入浴については、シャワーの場合、採取部位を濡らさないようにすれば翌日から、採取部位も含めた場合は2日後から可能です。入浴は抜糸後(約1週間後)から可能になります。
-
コンデンスセルチャー豊胸によって、しこりができる可能性はありますか?
ゼロとは言えません。しかし、セルチャー豊胸では不純物や老化細胞などを排除した脂肪と、脂肪の定着に有利に働く幹細胞を増量させて注入するため、従来法に比べればしこりのリスクは低くなると考えられます。また、当院では皮下、乳腺下、大胸筋内、大胸筋下の各層に少量ずつ丁寧に分散させて注入するマルチプルインジェクション技術を採用しており、こうした注入技術の点でもしこりの回避を図っています。万が一、術後にそういった問題が起こった場合は、最後までしっかりフォローしますのでご安心ください。当然、対応は無期限、費用は無料です。

-
乳がん術後の乳房再建の目的で、セルチャー豊胸を受けることはできますか?
はい、当院では乳がん術後の再建も行っています。施術を受けていただくには、乳がん治療の主治医の紹介状が必要です。
当院では一般病院の乳腺外科や形成外科と連携し、乳がんの術後の方に限り特別な価格でサービスを提供しています。
全摘出後の方は皮膚に余裕がないため、一度で十分な大きさを出すことは難しいことが考えられます。そういった場合は外側から皮膚を伸ばしていく専用の機器を体に装着いただきます。これによって、脂肪を注入するスペースを確保した上で、複数回に分けて脂肪を注入。数ヶ月かけて、少しずつバストアップを図ります。
乳がんのとき実際に受けた治療や手術内容、現在のお体の状態などを見させていただくことで、より詳しいご説明が可能です。
なお、当院は自由診療(保険外診療)のみを行っているため、乳房再建の場合も保険は適用されません。その点はご了承ください。
-
細胞を培養するとのことですが、初診から施術完了までどれくらいの時間がかかりますか?
施術は日帰りですが、細胞の培養に1カ月ほどお時間をいただきます。
まず医師によるカウンセリングを当院にて行います。その際、ご希望を伺うとともに施術の適応や脂肪の採取部位などを検討させていただき、お1人お1人に合った最適なプランをご提案いたします。次に培養するための脂肪を採取させていただきますが、こちらはカウンセリング当日に実施することも可能です。その後、幹細胞の培養に1カ月ほどお時間をいただいた後、改めて手術のためにご来院いただきます。培養後に施術を行うことになりますので、施術完了まで、早くても1カ月以上のお時間ががかかるとお考え下さい。

-
セルチャー豊胸は定着に有利とのことですが、それを裏付ける証拠はありますか?
注入した脂肪がどれほど定着しているかを示す例として、MRI画像をお見せできます。
こちらはセルチャー豊胸から6カ月が経過したバストの画像です。
白くなっている箇所が脂肪なのですが、術後、その面積が大きくなっていることは、見た目にもはっきりお分りいただけると思います。
脂肪は注入後3カ月で定着が完了すると言われているので、ここに描出されている脂肪は、ちゃんと組織の一部として定着した脂肪だと言えます。 -
モニターは募集していますか?
はい。モニター様は随時募集中です。
モニターと言えどもドクターをご指名いただくことも可能なので、ご希望があればお申し付けください(ただし、事前審査がありますのでその点のみご留意ください)。
-
幹細胞と一緒に脂肪の培養はできますか?
残念ながら、脂肪細胞を培養する技術はまだありません。ですからセルチャー豊胸と言えども、脂肪採取に伴う痛みや苦痛は、ある程度は避けられないとお考えください。
ただ、脂肪吸引によって美しいボディラインが手に入るいう利点もあります。
なるべく痛みや出血を抑え、お体に負担のかからない方法で脂肪吸引を行いますので、どうかご安心ください。
料 金
※当クリニックの価格は全て税込表示となっております。
THE CLINICが提供するコンデンスセルチャー豊胸(培養幹細胞豊胸)

施術料金
|
公的医療保険等が適応されない「自由診療」となります。表示価格は全て税込です。 |
会員価格会員価格は当院のプレミアムメンバーの価格です。 プレミアムメンバーには、ご来院時に無料でご登録いただけます。 |
ローン価格医療ローンは、審査により定められた利用可能額の範囲内で、治療費を分割で返済できるサービスです。ご希望内容や審査によって異なりますので、詳しくはお問い合わせください。 |
|---|---|---|
|
||
| 基本セット(消耗品・麻酔・内服薬) | ¥50,000(税込 ¥55,000) | ¥5,500/回〜 |
| コンデンスセルチャー豊胸(培養幹細胞豊胸) | ¥1,740,000(税込 ¥1,914,000) | |
- 脂肪採取料金が含まれております(メニューによって吸引範囲が異なります)
上記の費用プラス
| 会員価格会員価格は当院のプレミアムメンバーの価格です。 プレミアムメンバーには、ご来院時に無料でご登録いただけます。 |
ローン価格医療ローンは、審査により定められた利用可能額の範囲内で、治療費を分割で返済できるサービスです。ご希望内容や審査によって異なりますので、詳しくはお問い合わせください。 | |
|---|---|---|
| 乳腺エコー診断 | ¥0 | ¥5,500/回〜 |
| ダウンタイム軽減点滴(2バイアル) | ¥0 | |
| 他院バッグ取り出し | ¥200,000(税込 ¥220,000) | |
| 授乳後(バストトップデザイン) | ¥200,000(税込 ¥220,000) | |
| デコルテ・谷間オプション | ¥200,000(税込 ¥220,000) | |
| 乳頭縮小 | ¥200,000(税込 ¥220,000) | |
| ビブラ(乳房拡張機器) | ¥200,000(税込 ¥220,000) | |
| バストリフトSD | ¥300,000(税込 ¥330,000) | |
| エクスパレル(1cc) | ¥10,000(税込 ¥11,000) | |
| エクスパレル(1バイアル) | ¥100,000(税込 ¥110,000) |
ドクターカウンセリング
-

-

(カウンセラーのみのカウンセリングではございません)
お支払い方法
4種類のお支払い方法をご用意しております。併用していただくことも可能です。
- 現金
-
- デビットカード
- (ご利用可能金額は50万円まで)
-
- クレジットカード
- VISA、MasterCard、JCB、American Express、Diners、DISCOVER、銀聯
※事前に限度額をご確認ください

-
- 医療ローン
-
※審査によりご利用可能金額が異なります
- <お申し込みに必要なもの>
-
- 身分証明書(下記、いずれかをご用意ください)
- 運転免許証・パスポート・健康保険証のいずれか1点
- 金融機関発行のクレジットカード、またはキャッシュカードのいずれか2点
- 銀行通帳(郵便口座可)
- 銀行届出印鑑
- 身分証明書(下記、いずれかをご用意ください)
モニター
※当クリニックの価格は全て税込表示となっております。
-

モニター概要
募集内容 -
- セルチャー豊胸(培養幹細胞豊胸) パーツモニター
-
-
- 基本セット
- ¥100,000(税込 ¥110,000)
-
- コンデンスセルチャー豊胸(培養幹細胞豊胸)
- ¥2,800,000(税込 ¥3,080,000)
-
-
- ¥2,900,000(税込 ¥3,190,000)[一般価格]
- ¥1,540,000(税込 ¥1,694,000)
-

ボリュームアップ(女性/44歳) 
授乳後のたるみ(女性/40歳) 
ボリュームアップ(女性/40歳) 
ボリュームアップ(女性/35歳)
定員人数 先着5名限定 募集期間 応募条件 - 原則として18歳以上の男女
※未成年の場合、親権者がモニター施術に同意の場合のみ。 - 施術前、施術後に写真撮影をしても大丈夫な方
※WEBやメーカー資料として使用します。 - 施術後、アンケートにご協力いただける方
※WEBやメーカー資料として使用します。
ながれ - モニターお申し込み(電話またはネットから)
- モニター事務局より電話にてご連絡
- 来院日確定
- カウンセリング※診察の結果、不採用の場合もございますのであらかじめご了承下さい。
- 採用の場合、施術と撮影
- 当日/施術
- 後日/アフターケア・撮影
ネットからの
お申し込みお問い合せの入力フォームに必須項目をご記入ください。
※確認メール送信後、1営業日以内にモニター事務局より電話にてご連絡いたします。 -
施術の流れ

-
予約
お電話もしくはホームページから来院のご予約を申し込みください。
コンシェルジュがご希望の日程を調整し、お電話でご連絡します。-
- ネットからのお申し込み
-
-

+81-3-5775-3400(海外からの電話) -
- <受付時間>
- 10:00 - 19:00 完全予約制
-
-
-
カウンセリング
まずは、患者さまのご希望をお伺いします。
担当ドクターが経験に基づき、- 施術の適応性
- 脂肪を採取する部位
- 施術を行う優先順位
- 施術後の全身のバランス
- 年齢による変化
などを総合的に考慮しながら施術の内容をご提案します。また、術後の経過や注意点、考えられるリスクなどについてもご説明します。
-
施術日決定
必要に応じ、血液検査を行います。
その後、無理のない予算をご相談のうえでコンシェルジュが費用をお見積りしますので、施術当日になって課金されるようなことはありません。
施術予定日も、仕事のスケジュールやそれぞれの方の個人的な事情などをご確認して決定し、担当ドクターのスケジュールを押さえます。 -
脂肪採取
施術に先駆け、培養する脂肪幹細胞抽出のための脂肪を採取します。
採取量が20mLと低負担なので、局所麻酔でもそれほど痛みは感じません。 -
培養
採取した脂肪をもとに、再生医療センターで加工、脂肪幹細胞を培養します。1ヵ月程のお時間をいただきます。
-
デザインの確認
施術当日。最終的な施術の範囲をドクターが確認し、マーカーを用いてデザインします。当院の医師であれば、この段階で最終的な仕上りがイメージできています。
-
麻酔・施術
採取した脂肪を加工し、培養しておいた脂肪幹細胞を加えて、バストに注入します。
体への負担を考慮した静脈麻酔法が基本料金に含まれていますので、リラックスして施術を受けることが可能です。麻酔の点滴を開始すると気持ち良くなり、5分もするとウトウト眠ってしまいます。
適切な一定量の麻酔を維持して送り込んでいますので、施術中はほとんど痛みを感じることがなく、術後も入院の必要がありません。 -
施術後
術後はご気分が落ち着くまで、リカバリールームで休息いただきます。
処方薬や術後経過などのご説明の後、歩いて帰ることができますが、車の運転はお控えください。
施術概要
| 処置時間 | 事前の脂肪採取:15〜20分 豊胸手術:約2時間半 |
|---|---|
| 麻酔 | 事前の脂肪採取は、局所麻酔でも大きな痛みはありません。不安な方は眠った状態になる静脈麻酔もお選びいただけます。 豊胸手術の際は静脈麻酔を使用するので、手術中に痛みはありません。 |
| 傷跡 |
【バスト】 【脂肪採取部位】 |
| ダウンタイム |
【バスト】 【脂肪採取部位】 |
| シャワー | 事前の脂肪採取では、翌日から可能です。 豊胸手術でも採取部位以外は翌日から、採取部位も3日目から可能です。 |
| 入浴 | 事前の脂肪採取では、翌日から可能です。 豊胸手術後は抜糸後(約1週間後)から入浴できます。 |
| 治療の概要 | 事前に太ももなどから20ml程度の脂肪を採取し幹細胞を抽出、培養する。2週間後、老化細胞や血液等の不純物を除去した脂肪にこれを加え、バストの皮下に注入する。 |
| 副作用 リスク |
【バスト】 【脂肪採取部位】 |
THE CLINIC の技術
脂肪注入も脂肪吸引も、成否を分けるのはドクターの腕です。THE CLINIC は脂肪に関する施術を中心に扱う美容外科として、この2つの技術に自信があります。

THE CLINIC の脂肪注入
適正な注入量を判断
脂肪の大量注入は厳禁。皮膚の伸展(伸び具合)が関係するので注入量には個人差がありますが、その見極めが重要です。
当院では、術前のカウンセリングで立てた目安だけでなく、術中のバストの状態も見ながら注入量を個別に調整しています。

マルチプルインジェクション技術
いくら脂肪幹細胞が多くても、誤った注入方法では効果は見込めず、しこりのリスクも高まります。そのため、THE CLINIC では「マルチプルインジェクション技術」を徹底。脂肪が塊になることなく、より多くの脂肪を注入できます。
また、わずかな脂肪も無駄にしない「φ2.4mmヌードルインジェクション技術」の併用も可能です。

デザインを考慮
理想のバストの要素は大きさだけではありません。つまり豊胸手術は、単純に胸を大きくすれば良いというものではないのです。
バランスやフォルムなど、なりたいバストに近づくよう考えて注入することで、魅力的なバストを実現します。特に多くの人が胸のサイズとともに悩む、デコルテや左右差などの改善が喜ばれています。

THE CLINIC の脂肪吸引
カウンセリングでボディデザイン
コンデンスセルチャー豊胸は、脂肪吸引(採取)を伴う豊胸手術です。そのため、術前にしっかりボディデザインを練ることが重要。怠れば、脂肪の取り過ぎや不自然なボディラインになるなどの失敗を招きかねません。
まず、採取部位の脂肪の特徴や皮膚の状態、全身のバランスなどを確認。次にどこをどうするかをマーキングし、仕上がりイメージをゲストにも共有します。

他院への技術指導を担当
ベイザー脂肪吸引の症例数の多さを評価いただき、国内ドクターに対するベイザーの技術指導をお任せいただいています。

脂肪吸引の失敗修正も多数引き受け
バストのお悩みだけでなく、他院の脂肪吸引で失敗した方からも、多くのご相談が寄せられているTHE CLINIC 。豊富な修正手術の経験から、その原因についても熟知しているので、どうすれば失敗リスクを抑えられるかに関する知見を、豊富に蓄えています。
- 実際に修正相談のあった症例
-

関連コラム
関連施術

カウンセリング
幹細胞豊胸(再生医療)
ハイブリッド豊胸
豊胸トラブル
乳房再建
-

-
監修医師 大橋 昌敬 (THE CLINIC 総院長 / 日本美容外科学会専門医 / 日本美容外科学会会長)
胸部外科学などで博士号を取得した後、高水準の医療技術を求められるカナダで、心臓外科医として活躍。帰国後は「女性に最高の美しさを提供したい」という思いから美容外科医に転身する。
豊胸、脂肪吸引などでトータルボディデザインができる希少なドクターであり、圧倒的な症例経験と、他院向け技術セミナーの開催をライフワークとしていることから、国内随一の技術と熱意の持ち主として知られる。また、新しい美容医療技術の探求にも熱心で、海外の最新技術を習得する努力を欠かさず、学会での発表も積極的に行なう。
当院には、多種多様な専門医・認定医・学会員が在籍しています
<専門医/認定医>
日本美容外科学会専門医(JSAS)、日本形成外科学会専門医、日本形成外科学会指導医、日本形成外科学会 再建・マイクロサージャリー分野指導医、日本形成外科学会 小児科形成外科分野指導医、日本泌尿器科学会専門医、乳房再建用エキスパンダー/インプラント 責任医師、日本頭蓋顎顔面外科学会専門医、コンデンスリッチファット(CRF)療法認定医、VASER Lipo認定医、VASER 4D Sculpt 認定医、TOTAL DEFINER by Alfredo Hoyos 認定医、サーメージ認定医、カンタースレッズ認定医、Botox VISTA認定医、Juvederm Vista認定医、ビスタバイクロスシリーズ認定医、日本胸部外科学会認定医、日本外科学会専門医、日本消化器外科学会消化器癌外科治療認定医、日本がん治療認定医機構がん治療認定医、マンモグラフィ読影認定医、日本抗加齢医学会専門医、日本麻酔科学会 指導医、蘇生法指導医、日本心臓血管麻酔学会 指導医、日本老年麻酔学会 指導医、日本専門医機構 麻酔科専門医、アメリカ心臓病協会BLS・ACLSプロバイダー、日本呼吸器外科学会認定登録医、日本呼吸器学会専門医
<所属学会>
日本外科学会、日本臨床外科学会、日本胸部外科学会、日本消化器外科学会、日本形成外科学会、日本呼吸器学会、日本内視鏡外科学会、日本泌尿器科学会、日本美容外科学会(JSAS)、日本美容外科学会(JSAPS)、日本乳癌学会、日本乳房オンコプラスティックサージャリー学会、日本内分泌外科学会、日本甲状腺外科学会、日本頭蓋顎顔面外科学会、日本麻酔科学会、日本蘇生学会、日本臨床モニター学会、日本心臓血管麻酔学会、日本老年麻酔学会、日本臨床麻酔学会、日本医療ガス学会、米国麻酔学会(ASA)、米国形成外科学会(ASPS)
本サイトは医療広告ガイドラインを遵守した情報を掲載しています
THE CLINIC では、医師監修のもと「医療広告ガイドライン」に則り、以下の2点を遵守するとともに、状況に応じた改善を適宜行っています。
1. 治療に関する体験談は掲載致しません。
2. 症例写真を掲載する際は、施術内容とリスク、および標準的な価格を必ず明記します。














































コンデンスセルチャー豊胸は、人工培養で増殖させた幹細胞を用いる再生医療豊胸術です。
THE CLINIC では提供する院の「第二種再生医療等提供計画」を提出し、地方厚生局に受理されており、正式な手続きの下で施術を行っています。